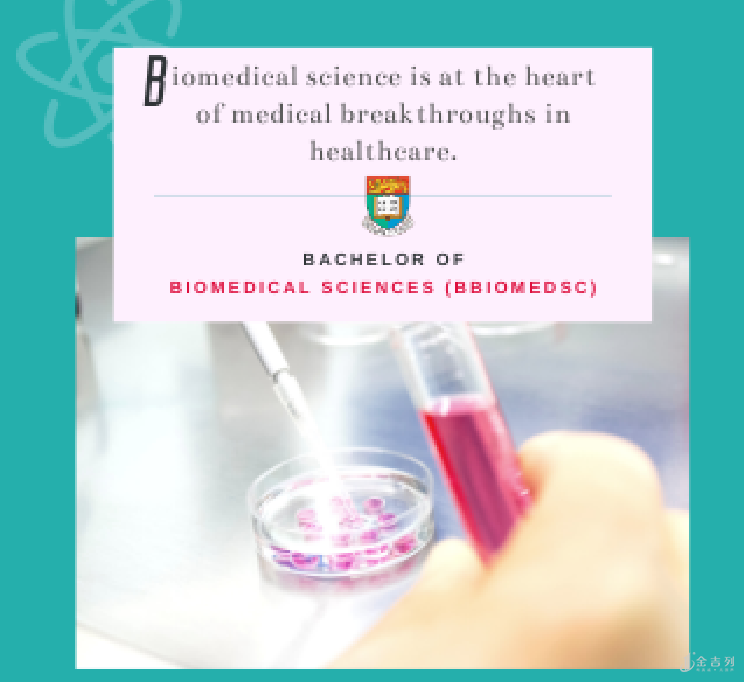

港大生物医学学土课程内容分析
略微了解港大一点的同学们都了解,港大诚先生医学院,有诸多“神科”,每一年吸引住着来源于全世界的优秀生报名
从沙宣道(注:港大医学院所在城市)圆满大学毕业的医科大学学员,常常变成各制造行业,尤其是医疗界思贤若渴的目标
今日大家就而言说,神科之一的生物医学学土Bachelor of Biomeical Sciences。
LKS Faculty of Meicine · HKU
香港大学医学院是中国香港名牌大学中历史时间最久远的学校。于1887年由纽约传导会开创,原称“中国香港中国人西医方面私塾”,后于1907年易名为“中国香港西医方面私塾”。1911年,香港大学宣布创立,中国香港西医方面私塾划入香港大学,变成高校的首例学校。2006年,港大获诚先生老先生10亿人民币捐赠,同一年医学院取名为“诚先生医学院”。以往130很多年来,医学院一直领导干部诊疗文化教育与专业技能培训的发展趋势。
香港大学在 2013 年发布生物医学课程内容,是中国香港第一个该类课程内容。医学院有着国际级的老师团体、临床医学单位、基础学科单位及科学研究试验室,为临床医学们做好高品质的基本。并且,远眺海景别墅的港大医学院确实很漂亮很大气呀你看看~
生物医学学土详细介绍
生物医学包括普遍的生物科学及有关的课程,例如分子与细胞生物学、细胞生物学和基因组科学研究、生物新闻资讯学、人体解剖学、生理学、药理学、生物与临床药理学、医学免疫学、微生物学、公共卫生服务等。生物医学主要人们与身心健康和病症中间的关联,及将基础学科基础理论运用至健康医疗和保健医疗行业等层面的临床护理。
肺炎疫情期内,香港大学医学院好几个科学研究团体发布科学研究超重量级成效。这种科学研究 都归属于生物医学的科学研究层面。 比如,4月初香港大学微生物系团体与中国香港玛丽医院相互公布相关新冠病毒的全新科学研究: 历经以人体肺部机构为实体模型,比照新式新冠病毒与SARS病毒感染在人体内的感柒状况后,发觉以两天内病毒繁殖速率测算,新冠病毒在人体内的繁育量高于SARS病毒感染3倍上下。 疫苗研发、高通量测序、攻破癌证、干细胞美容生物学…这种都可能是生物医学学员将来的研究领域。 假如你要变成将来的生物医学生物学家,根据科学研究的方法为人们身心健康工作贡献力量,热烈欢迎报名港大生物医学学土!
课程内容构架及主修科目一览
生物医学主学课程内容>>
全部课题设计四年进行,需修满 240 个学分制。 主学课程内容有三个重中之重,包含生物科学与身心健康、病症的体制和缘故,及其生物医学有关的科技前沿。
学员必须进行的基本必修课有 :
人们生物学/生物有机化学未来展望/生物统计分析/通用性基础化学/生化实验室基础方法;
及下列报表内随意四门课 :
人类基因学/新手入门人体解剖学 / 生物医学药学…等,详细下面的图:
除基本课程内容外,学校还将出示下列进阶学习课程内容 :
医药学微生物学/分子结构认知科学/编码序列生物信息学/康复治疗科学研究/分子诊断试验室等, 详细下面的图:

辅修及选修课>>
港大亦激励 学员依据自身的兴趣爱好挑选辅修课程内容。学员可挑选生物医学学系的三门辅修:生物技术性与临床实验,遗传基因和基因组学科学研究,及运动学,或挑选跨学校辅修或选修课。 详细信息能致”阅读“官方网站查询。
对接课程内容
读医一般不仅于大学本科,再次学习的概率十分大。港大生物医学技术专业给与同学们十分大的协调能力, 全部生物医学学员在大三这一年能够 挑选申请办理对接方案,包含国外名牌大学及该校的第二学位课程内容和本硕连读。

爱丁堡学校宠物医生学士学位证书 对接方案>>
合资质的同学们 可于爱丁堡学校以选修课方式攻读宠物医生课程内容,更快可于七年内获得港大生物医学学土及爱丁堡学校宠物医生学士学位证书。
澳洲悉尼大学物理医治研究生课程内容/放射性确诊研究生对接方案>>
合资质的同学们 可于课程内容的第三年挑选报考此二项对接方案,更快可于五年半内获得港大生物医学学土,及悉尼大学物理疗法研究生或放射性确诊研究生学位。
英国加州伯克利高校公共卫生服务研究生课程内容对接方案>>
合资质的同学们 更快可于五年三个月内进行港大生物医学学土,及加州伯克利高校的公共卫生服务研究生学位。
港大內外全科医学士对接方案>>
合资质的同学们于进行四年的生物医学学土课程内容后,可立即就读港大內外全科医学士的第二年,更快可于八年内获得港大生物医学学土及內外全科医学士学士学位。
大学毕业动向

生物医学学土的大学毕业生可投身于不一样层面的工作中,包含从业高校,政府部门,医疗器械企业及生物技术性组织等试验室科学研究工作中;药品,医用品及仪器设备等产品研发及有关产业链的管理方法和市场拓展;临床试验管理方法;文化传媒,媒体公关;公营定点医疗机构现行政策及行政部门等。同学们亦具有牢固基本再次攻读和学习研究生,博士研究生,医药学,动物医学以及他诊疗课程。
二十一世纪的人们在绿色生态和身心健康上遭遇着史无前例的不容乐观挑戰,而生物医学也许是时下最急切的必须。将要投身于此项杰出的工作的大家怀里理想,港大会为大家助推给油,大风大浪当中服务保障。